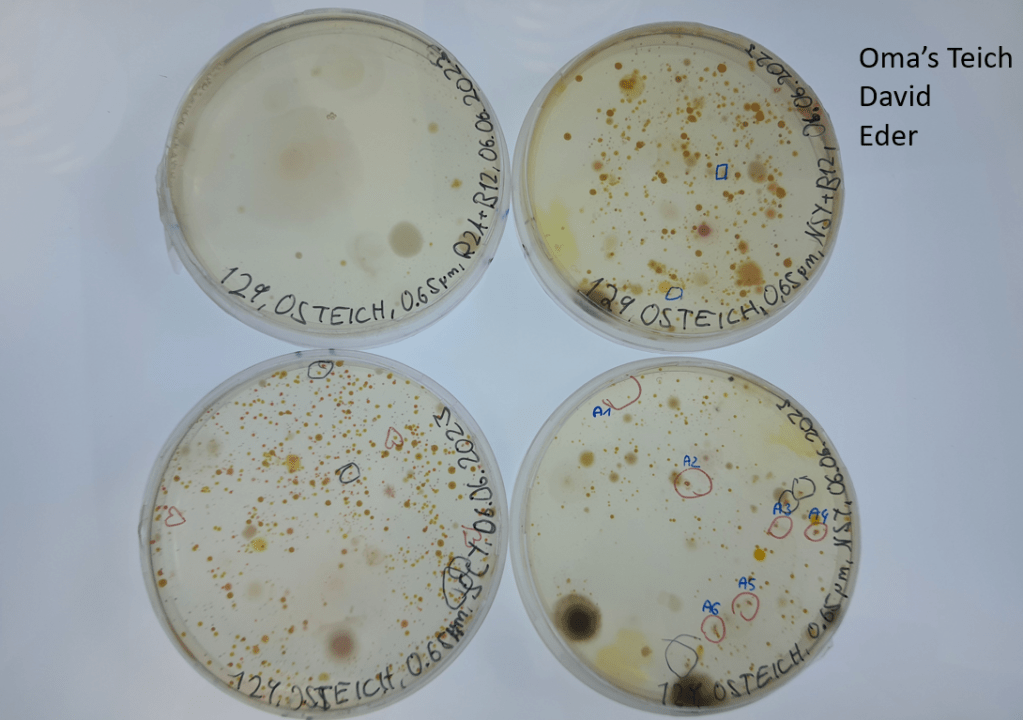
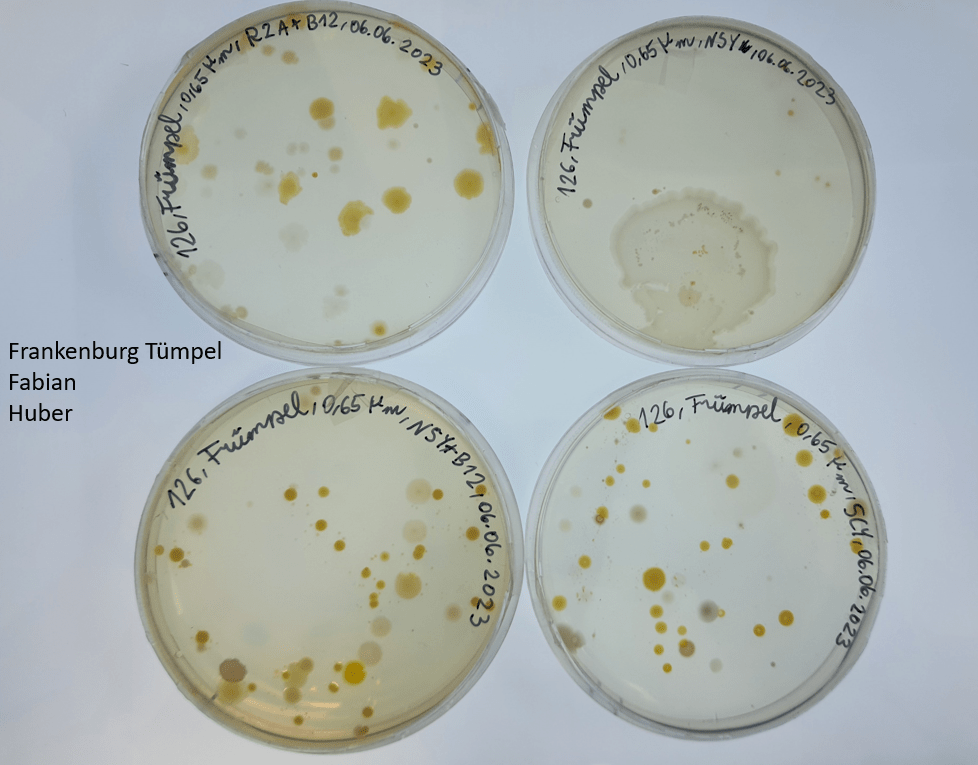
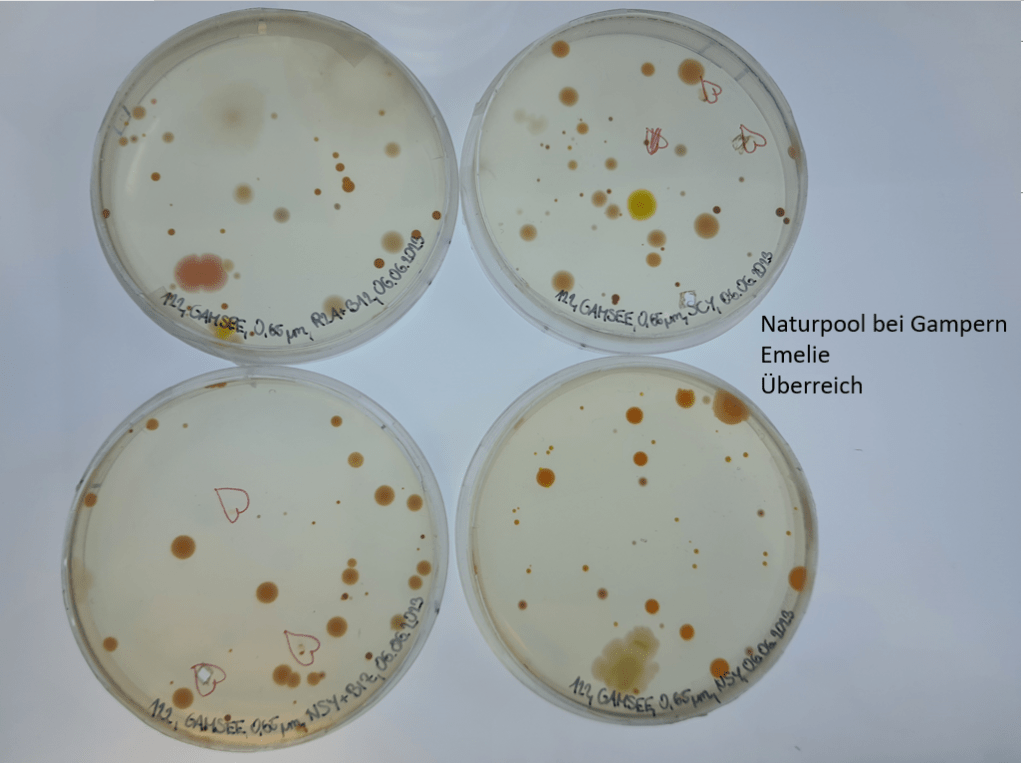
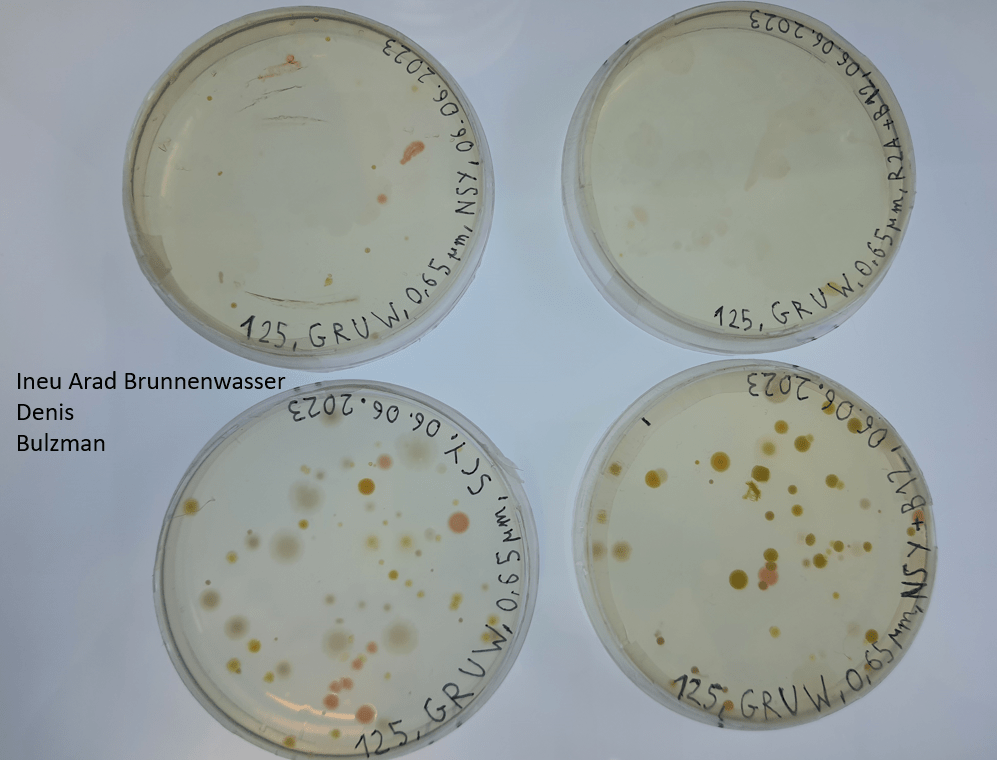
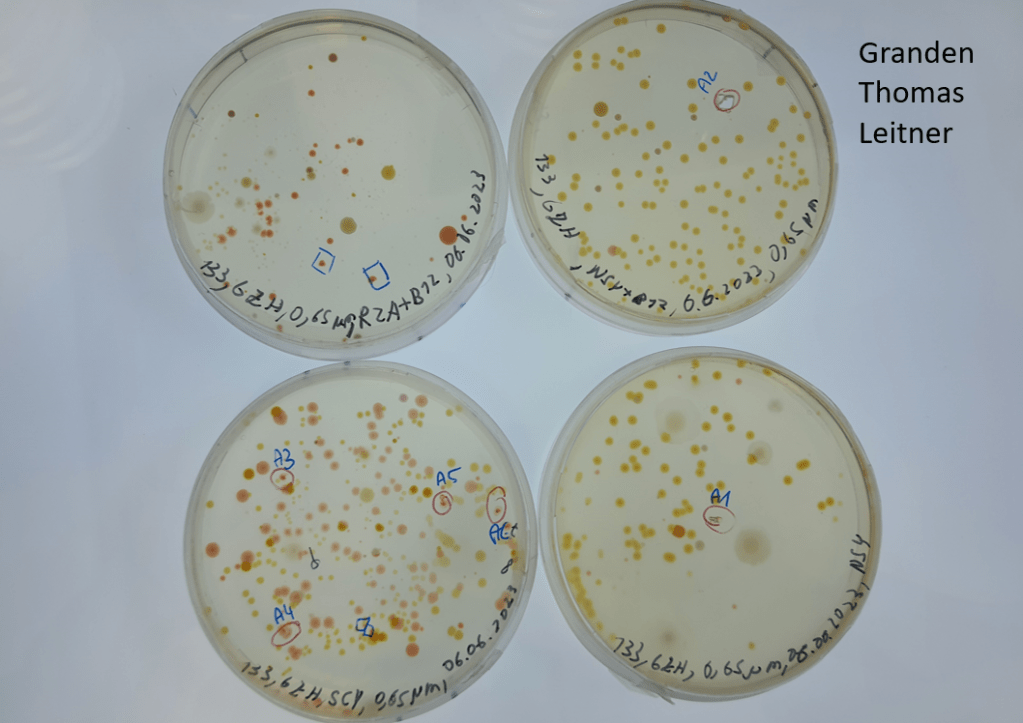
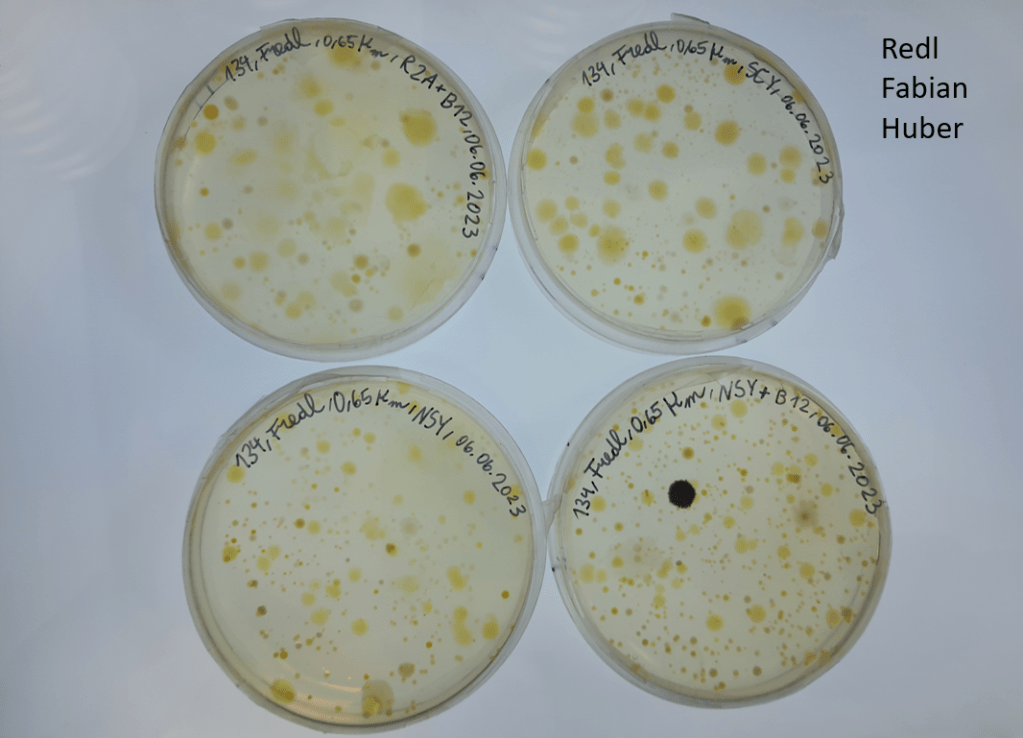
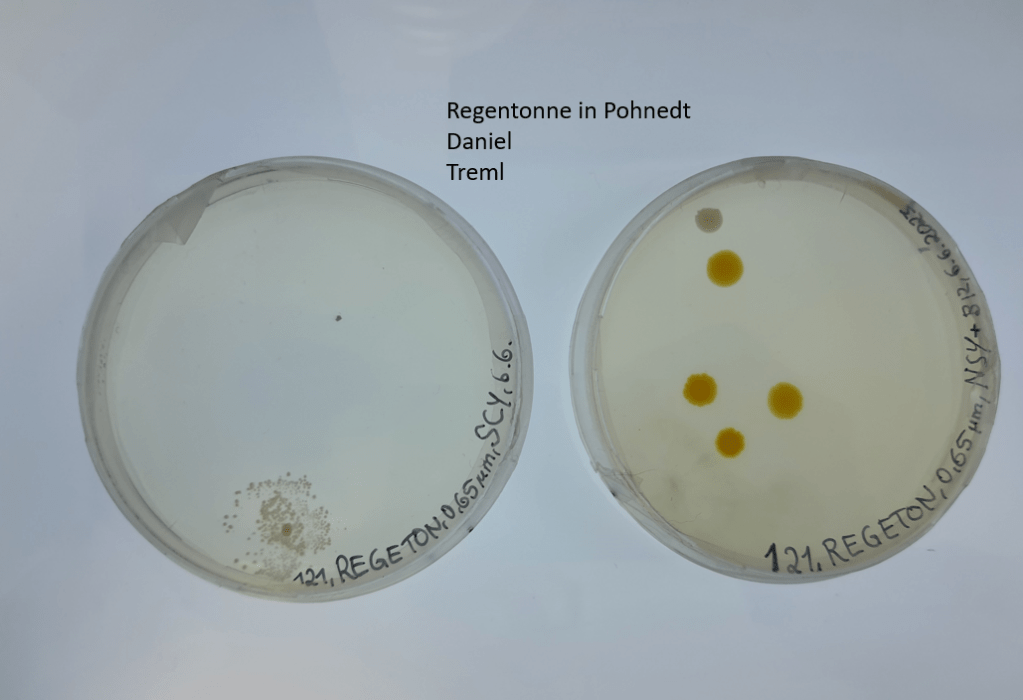
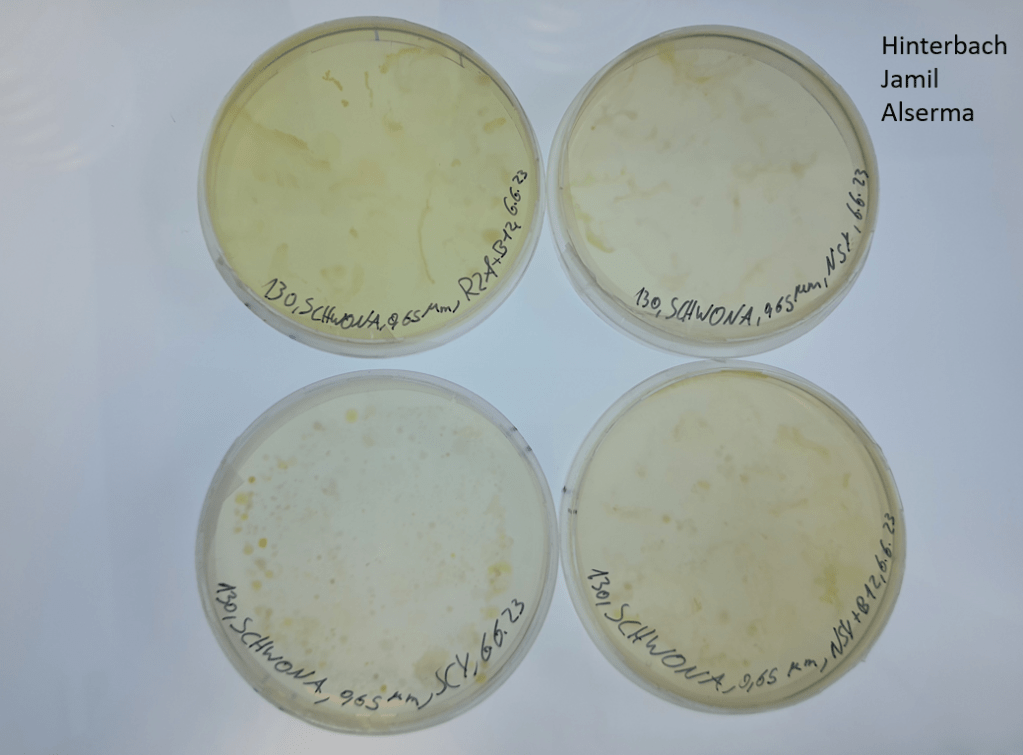
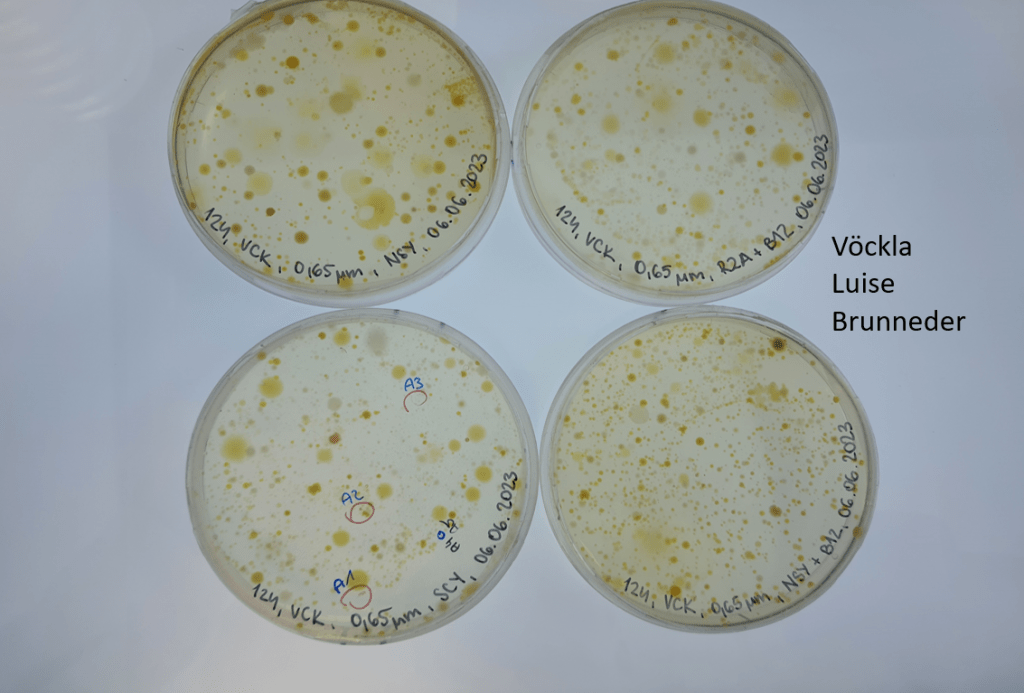
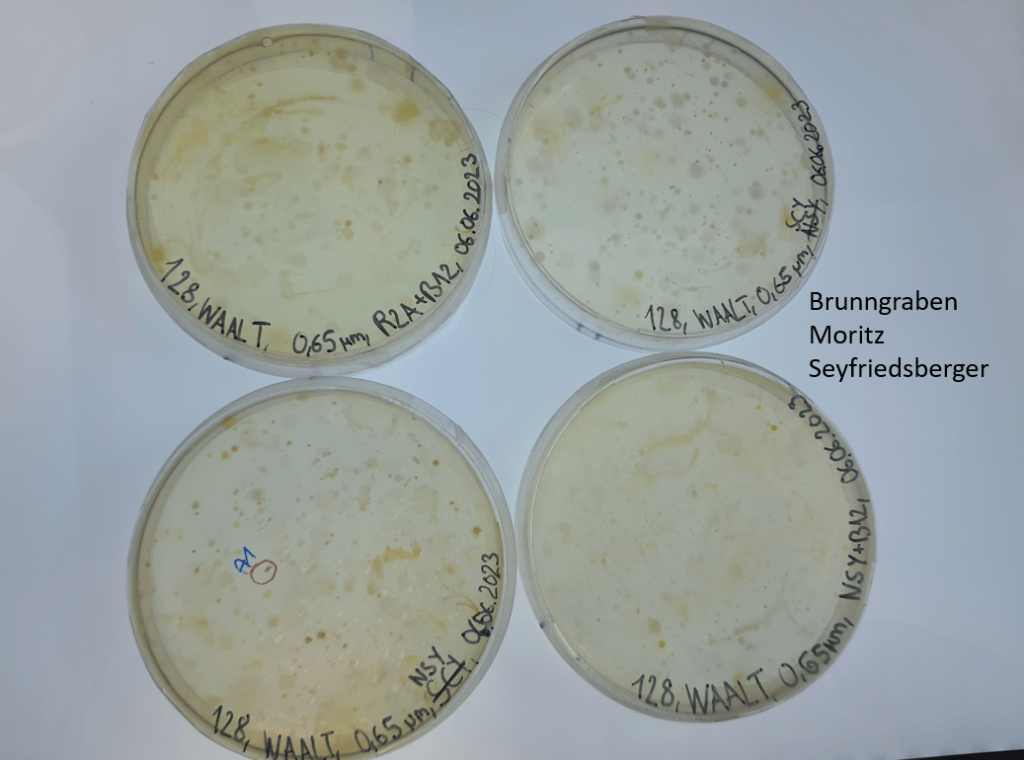
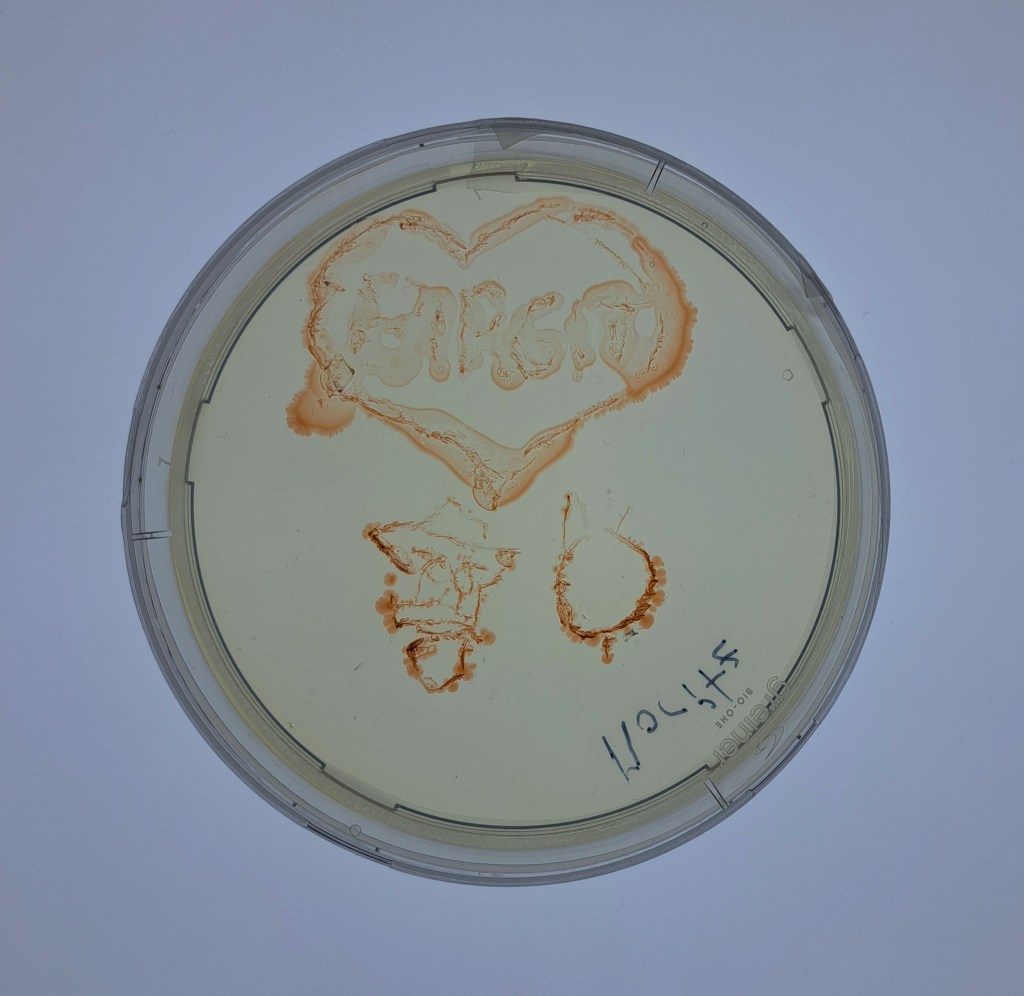
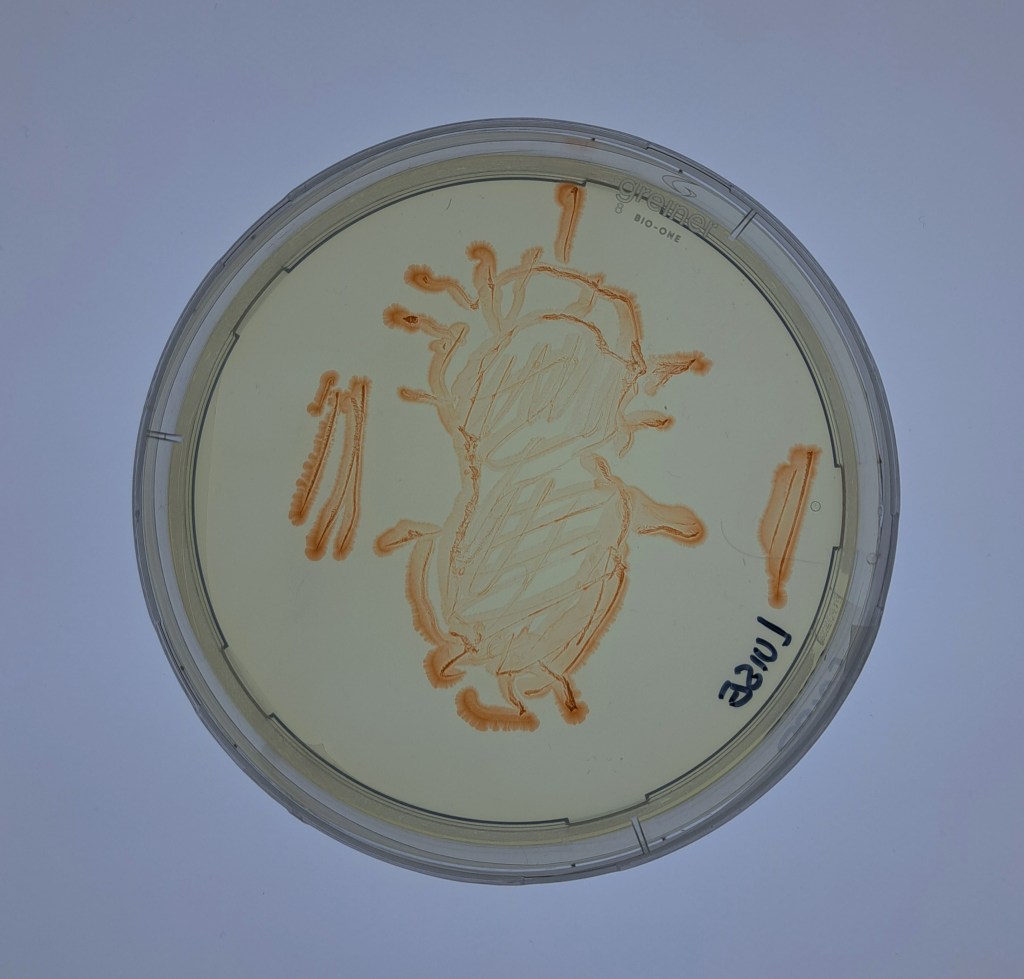
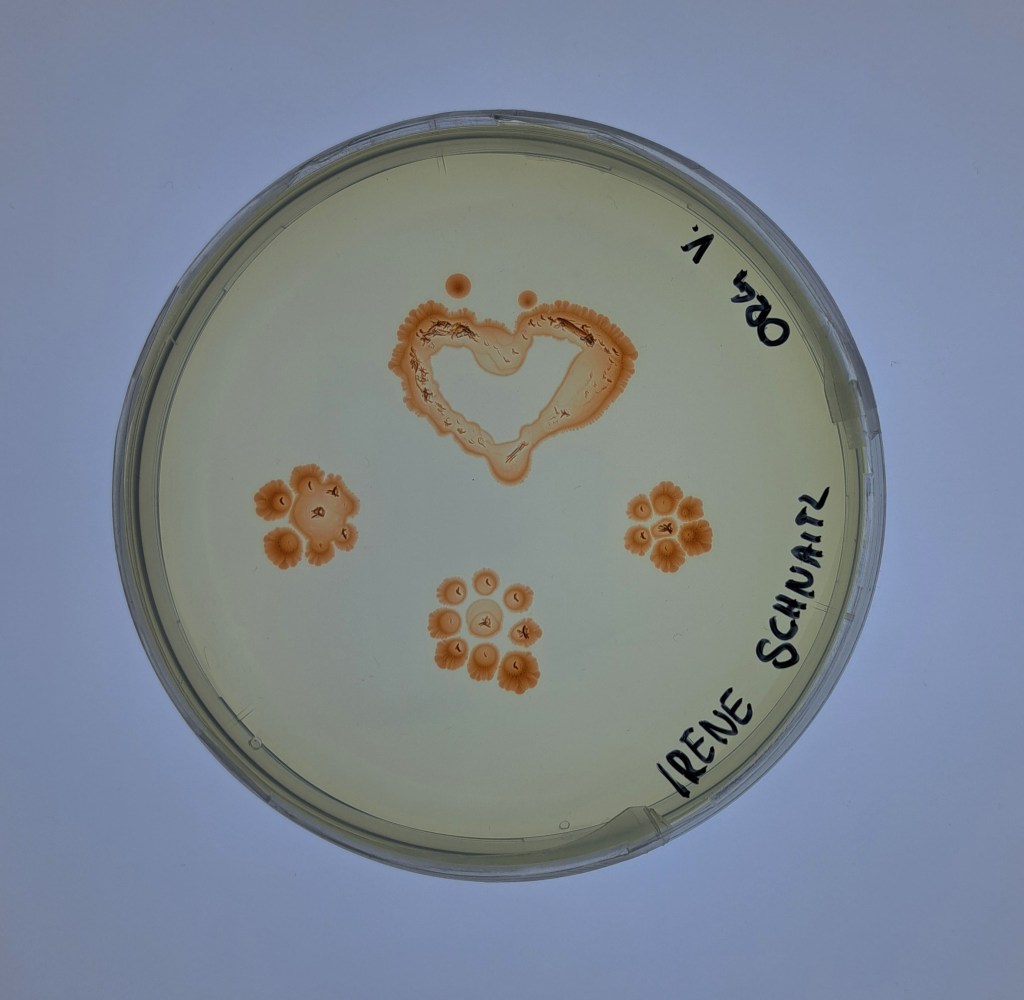
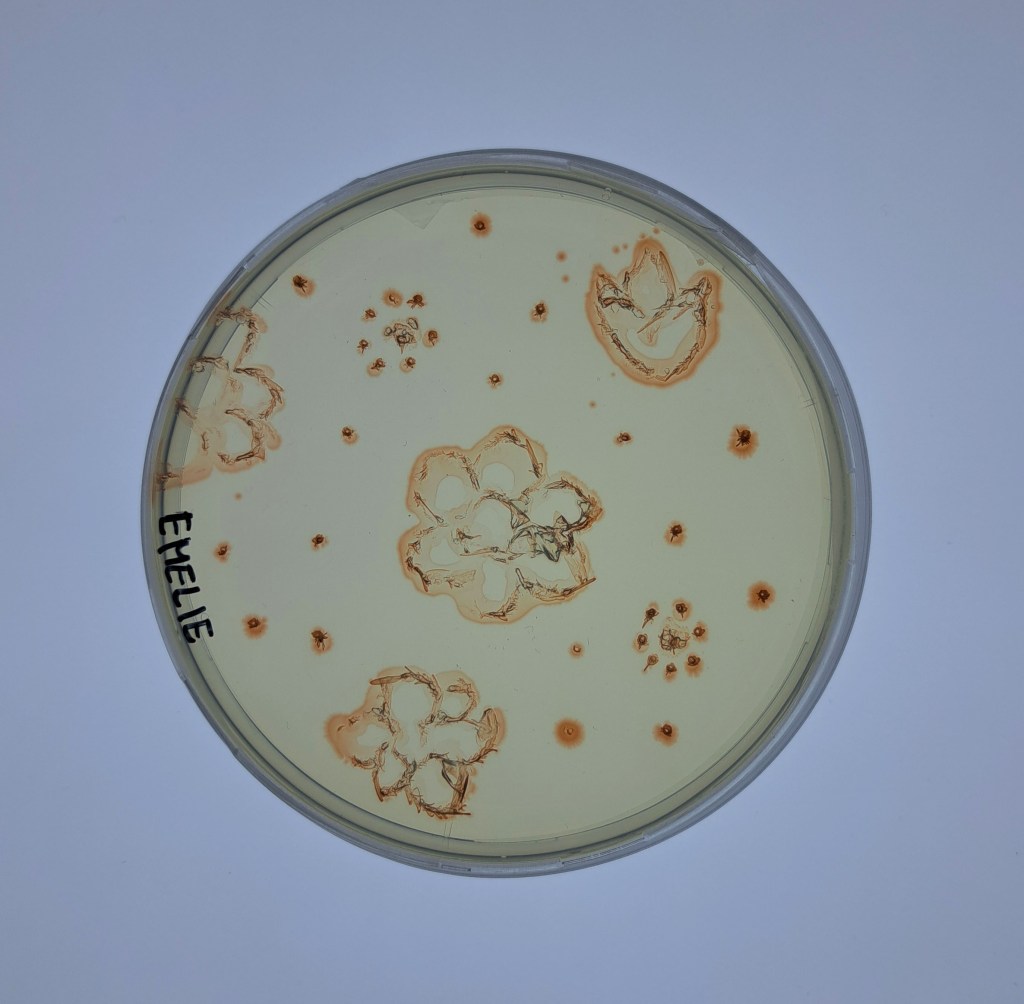
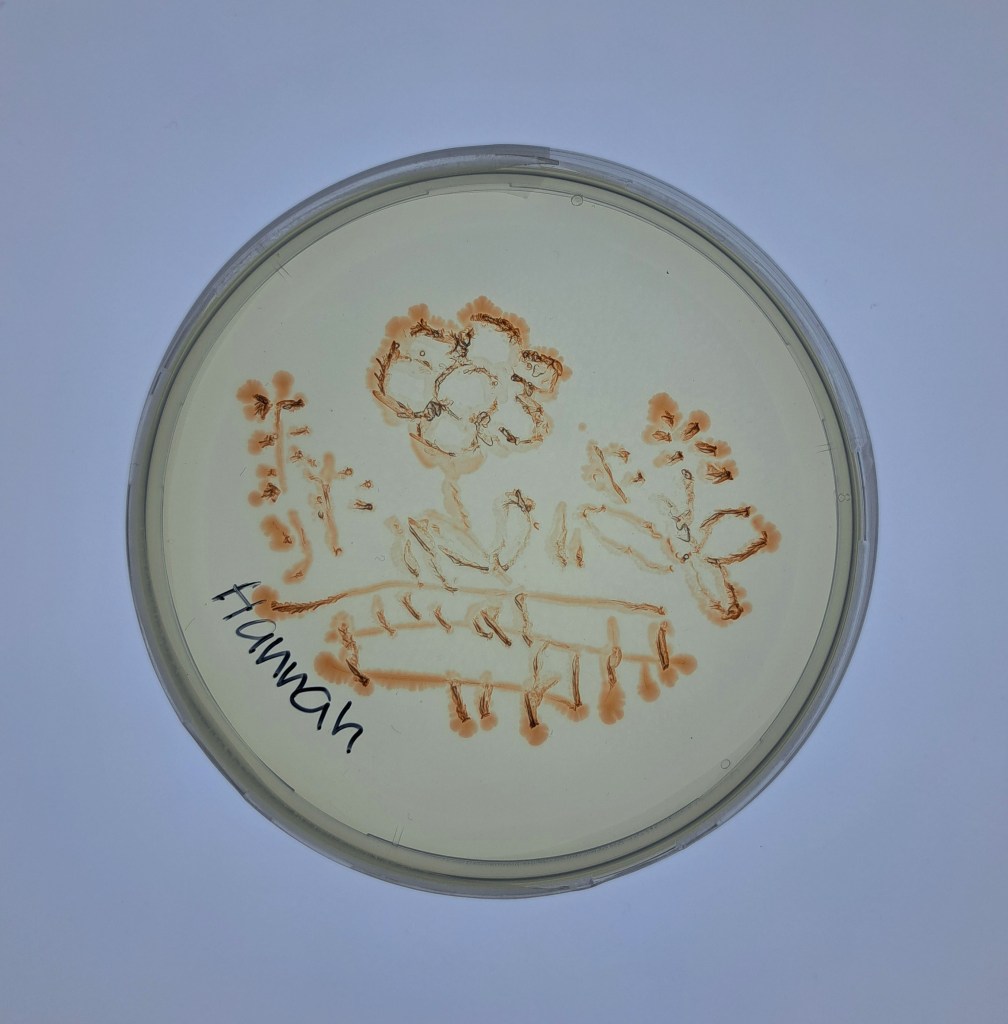

Klasse 6c (2022/2023) mit Irene Schnaitl

1. Workshop
Am 24.5.2023 waren Alexandra und Stefan zum ersten Mal beim Privaten ORG Vöcklabruck des Vereins für Franziskanische Bildung zu Gast. Obwohl Johanna diesmal in Mondsee geblieben war, zum gesamten Beitrag

2. Workshop

Am 6.6.23 waren Alexandra und Stefan wieder bei der 6c im ORG Vöcklabruck zu Gast. Mit den nur 11 Schüler/innen war es wieder ein gemütlicher Vormittag. zum gesamten Beitrag
3. Die Gewässerproben
Hier sind Fotos von der von den Schüler/innen mit ihren gesammelten Wasserproben beimpften Agarplatten. Auf manchen Platten haben wir schon interessante Kolonien entdecken können, man erkennt sie an den Markierungen auf dem Boden der Agarplatten. Vielen Dank an unseren Sommerpraktikanten Tobias von der HBLA fürs Fotographieren und Beschriften der Fotos 🙂
4. Der Weg zu den Aquirufa Kulturen
Von den Agarplatten haben wir uns die Kolonien rausgesucht, die das typische ‚Aquirufa-Rot‘ zeigen. Diese haben wir vorsichtig mit einem (sterilisierten 😉 ) Zahnstocher in flüssiges Medium gegeben (Platte links). Dort konnten sich die Bakterienzellen weiter vermehren. Wenn die Kultur das typische Rot aufwies, haben wir davon wieder ein wenig auf eine Agarplatte pipettiert und mit einer Impföse (das sind die langen Stäbe im Bild) verteilt.

Im Bild sieht man die Flüssigkulturen. Sie stehen auf einem Schüttler in kleinen Erlenmeyerkolben und werden leicht geschaukelt, damit die Bakterien genug Luft bzw. Sauerstoff zur Verfügung haben. Inzwischen haben wir eine ganze Menge davon und müssen aufpassen, dass wir noch den Überblick behalten 😉 .

Und so sieht unser Fach im Kasten mit den Kulturen auf Agarplatten aus. Es sind ebenfalls eine ganze Menge. Zur Aufreinigung wird jeweils eine Kolonie aus einer Agarplatte ausgestochen und in flüssiges Medium gegeben. Das wiederholt man vier Mal, um eine Reinkultur, also eine Bakterienkultur, die nur Zellen von einem einzigen Bakterienstamm enthält, zu bekommen.

Um zu erfahren, ob die erhaltenen Bakterienstämme wirklich zur Gattung Aquirufa gehören, wird ein kleiner Abschnitt der DNA sequenziert. Dazu machen wir erst eine PCR und schicken das erhaltene Material zu Eurofins nach Deutschland.

Inzwischen haben wir aus vier Gewässern von den Wasserproben des ORG Vöcklabruck Bakterienkulturen, die zur Gattung Aquirufa gehören. Das sind weniger Gewässer als bei den anderen Klassen, aber dafür sind diese sehr interessant. Aus einem Gewässer haben wir Kulturen von drei Arten bekommen können und eine neue Art ist vielleicht auch dabei. Um das sicher sagen zu können müssen wir noch von einigen Bakterienstämmen das gesamte Genom sequenzieren lassen.
Und das sind die Gewässer, aus denen wir bis jetzt Aquirufa-Kulturen erhalten haben: Vöckla (VOEWA-120, Lina Sophie Ematinger), Vöckla (VCK-124, Luise Brunneder), Omas Teich 🙂 (OSTEICH-129, David Eder), Granden zu Hause (GZH-133, Thomas Leitner).
5. Workshop zum Auswerten der Daten
Am 28.03.2024 waren Stefan und Alexandra nochmal im ORG Vöcklabruck in der inzwischen 7. Klasse zu Besuch. Gemeinsam haben wir uns angeschaut, aus welchen Wasserproben wir Bakterienkulturen gewinnen konnten, die zu unserer gesuchten Gattung Aquirufa gehören. Die Schüler/innen konnten die erhaltenen Sequenzen (das ist die Buchstabenabfolge in der DNA) selber analysieren. Die Bakterienstämme aus der Vöckla und aus dem Granden konnten sie bekannten Aquirufa Arten zuordnen. Aus Omas Teich konnten wir sogar Bakterien, die zu drei verschiedenen Aquirufa Arten gehören, in Kultur nehmen. Zwei dieser Arten stellen neue, noch unbeschriebene Arten da. Das hat sogar uns überrrascht. Sie werden demnächst wissenschaftlich beschrieben werden. Davor gibt es aber noch einiges zu tun, da werden die Praktikant/innen im Sommer mithelfen.
6. Artikel in tips Vöchlabruck vom 1.3.2024
Vöcklabrucker Schüler entdecken neue Bakterienart hier gehts zum Artikel
7. Namensuche
Die -inzwischen- 7. Klasse gemeinsam mit ihrer Biolehrerin und ihrem Lateinlehrer einen Namen für die neu entdeckte Art aus Omas Teich, das ist der Gartenteich von Davids Oma, kreiert. Vorgeschlagen wurde Aquirufa avitistagni zusammengesetzt aus den lateinischen Wörtern für großmütterlich und Teich. Unser israelischer Kooperationspartner Prof. Oren wurde als Spezialist für die Namensgebung um Rat gefragt. Der Name ist grammatikalisch korrekt und wurde zudem sehr gelobt 😊. Uns freut das sehr, es ist das erste Mal, dass ein aus mehreren Wörtern zusammengesetzter Name auf Anhieb allen Regeln entspricht 😎. Herzlichen Glückwunsch an das Team vom ORG Vöcklabruck.

8. Praktikum von Hannah und Thomas

Unsere zwei Sommerpraktikanten Hannah und Thomas vom ORG Vöcklabruck waren sehr fleißig im Labor. Dank ihrer Mitarbeit können wir bald die nächste Artbeschreibung einreichen. Hier ist ihr sehr netter Bericht vom Praktikum:
„Wir besuchten vier Wochen lang ein Praktikum.. hier gehts zum Beitrag
9. Sommerprobenahme am Mondsee
Bei herrlichem Wetter haben wir unsere Sommerprobenahmen am Mondsee durchgeführt. Mit dabei waren unsere drei Praktikant/innen Hannah, Sophia und Thomas hier gehts zum Beitrag

10. Besuch im Forschungsinstitut in Mondsee

Am 23.10. war ein ganz besonderer Tag bei uns im Forschungsinstitut in Mondsee. Erstens waren unsere Kooperationspartnerinnen von der Deutschen Sammlung von Mikroorganismen und Zellkulturen Jacqueline Wolf und Meina Neumann-Schaal bei uns zu Besuch und außerdem unsere Klasse vom ORG Vöcklabruck mit ihrer Lehrerin Irene Schnaitl. hier gehts zum Beitrag
11. Die Kunstwerke
Bei ihrem Besuch in Mondsee hatten die Schüler/innen mit unseren roten Aquirufa Kulturen auf Agarplatten ‚gemalt‘. Dabei sind tolle Kunstwerke entstanden:
12. Publikation erschienen

Wie freuen uns sehr, dass unsere zweite wissenschaftliche Publikation im Projekt online erschienen ist. Untersucht haben wir dabei vier Gewässer im Renaturierungsgebiet der Weitwörther Au im Hinblick auf unsere Gewässerbakterien. Wir haben dabei zwei neue Arten entdeckt…hier gehts zum Beitrag
13. Wissenschaftliche Publikation erschienen
Unsere 3. wissenschaftliche Publikation ist erschienen und hier online verfügbar. Ca. 130 Citizen Scientist haben dabei mitgewirkt. Sechs Schulklassen und weitere Citizen Scientists haben Wasserproben aus selbst gewählten Gewässern genommen…hier gehts zum Beitrag